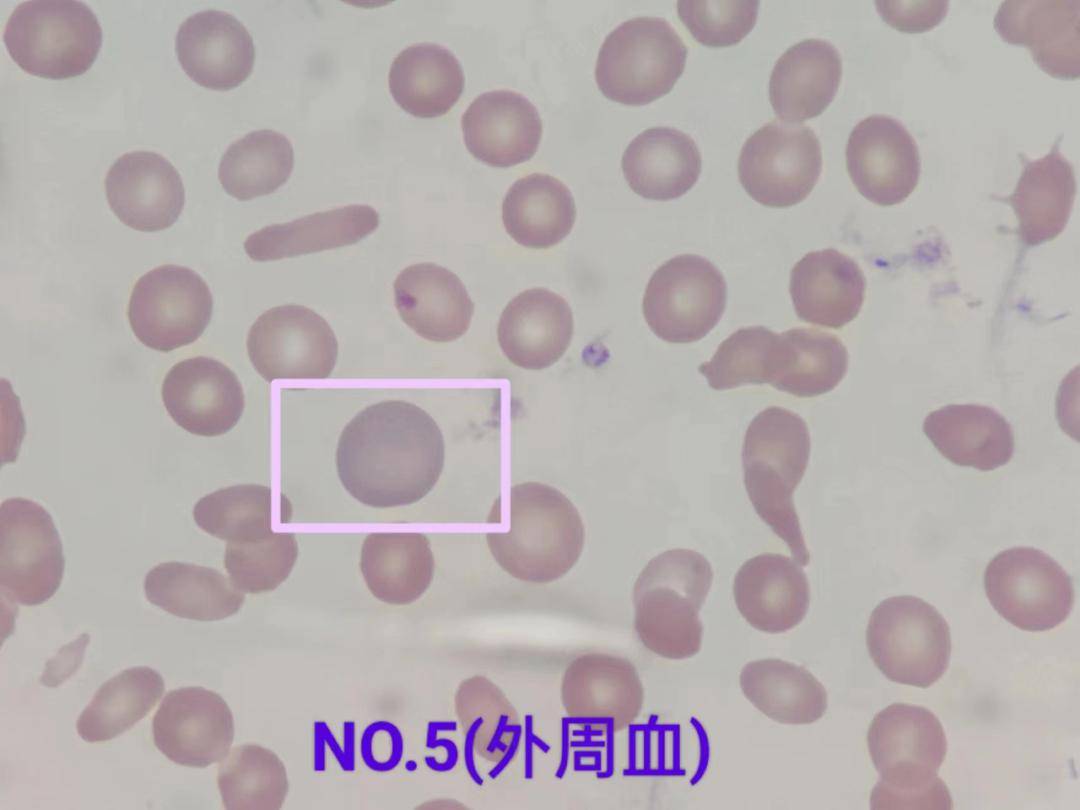
看图识细胞(第125期)_检验_形态学_来源

胞质面

完整版称为核孔复合体cytoplasmicface胞质面nuclearface
图片尺寸960x720
糖萼 糖脂和糖蛋白上所有的糖类都位于 膜的非胞质面一侧
图片尺寸1080x810
支持细胞 (sertoli
图片尺寸500x375
外核膜胞质面附有核糖体,并与内质网相连,核周隙与内质网腔相通,可以
图片尺寸576x414
中间连接 intermediate junction 位置:多位于紧密连接下方 结构:细胞
图片尺寸1080x810
看图识细胞第23期细菌篇
图片尺寸704x503
细胞生物学:膜的不对称性(membrane asymmetry)
图片尺寸350x292
细胞的重要作用(细胞具有什么作用)
图片尺寸1080x697
过多/过大的空泡都会削弱胚胎发育潜能;,胞浆内滑面内质网聚集的卵子
图片尺寸680x228
看图识细胞(第125期)_检验_形态学_来源
图片尺寸1080x810
看图识细胞(第125期)_检验_形态学_来源
图片尺寸1080x810
8微米的泡状结构,内含许多水解酶,溶酶体在细胞中的功能,是分解从外界
图片尺寸800x771
看图识细胞(第125期)_检验_形态学_来源
图片尺寸1080x810
总论(上课)ppt
图片尺寸1080x810
细胞质膜与细胞表面详解.ppt 142页
图片尺寸1152x864
细胞质——核周质 神经元的细胞质内含有一般细 胞器如 线粒体——供
图片尺寸1080x810
细胞_能量_皮肤
图片尺寸555x454
看图识细胞第23期细菌篇
图片尺寸1080x772
腾讯新闻
图片尺寸212x320
花蜜瓣上的些一胞(细能够分泌具有芳气香的味质)物
图片尺寸1080x810